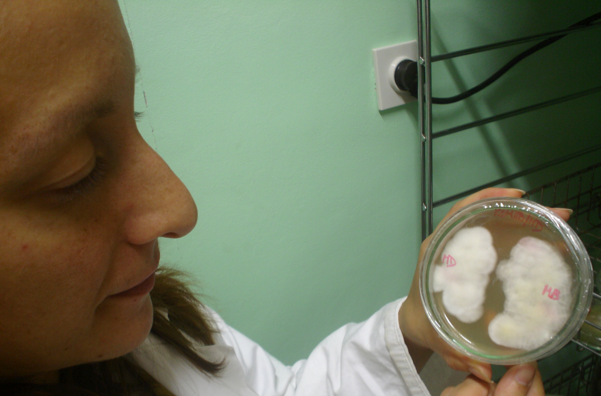

Our concept is to cultivate and process fungi and mushrooms to final products completely independently, in an environmentally friendly manner, on the highest quality level for our consumers. We have complete control over the whole production process, from the initial fungal culture and composition of the growth substrate, to the methods of final processing into food supplements. Since we control every aspect of the manufacturing process and the products are regularly tested, we completely guarantee the quality of our products.

It all starts with isolation of fungal culture
Our production is environmentally friendly, which means we only use recyclable materials, our premises are heated exclusively with renewable wood biomass and residual energy from drying processes. All fungal substrates are composted after use, for cultivating garden crops. Moreover, in the manufacturing process we do not use any chemical preparations, but only everyday cleaning products.
We are aware that the quality of conventional raw input materials is increasingly questionable, due to the use of various pesticides and GMOs in farming. Therefore, only 100% organic raw materials provided by verified suppliers from the European Union are used in our production process. Furthermore, we are located in a peaceful natural environment which, in our opinion, increases the quality of our products






Examples of our mushroom species
End products produced from medicinal fungi and mushrooms are supplied in bulk to many pharmaceutical companies, at home and abroad. They are used in different brands of foods, feeds, cosmetics etc. In addition, for some companies we also customarily manufacture products for their own brand labels.
We possess the largest collection of medicinal and edible fungi in the country
Our trademark GOBA® comprises high-quality products from medicinal fungi for human use and pets. These are marketed by national as well as international distributors.
The quality of our products is regularly monitored by our laboratory, by certified national quality control laboratories and certified international laboratories, as well as by research institutions at home and abroad. However, for us the best conformation is a vast number of satisfied customers, who regularly use and benefit from our products.
Analysing medicinal compounds from mushrooms and their preparations
We are one of the leading European manufacturers who cultivate fungi 100% organically. Our products are made exclusively from our own raw materials and materials of a 100% European origin. Thus, we support European suppliers and avoid the import of inexpensive low-quality raw materials.

Sterile cultivation techniques
Despite the fact that we are one of the leading European manufacturers of food supplements from medicinal fungi, still a large amount of our resources and time is invested into further development of new processing technologies to improve our products. The research is carried out by our own development team or in collaboration with various national and international research institutions. So we also strive to expand our understanding of medicinal fungi and their modes of action and put a lot of effort into spreading this knowledge.
Presenting research results at intenational conferences
The mushrooms used in our products are cultivated in a clean rural environment, according to the European Union guidelines for organic production.
A valley where MycoMedica Ltd is situated in
Our own development and technology of production guarantee high quality and traceability of the entire manufacturing process – from culture cultivation and processing to the final product. Thus, we ensure that our products do not contain any harmful microbes nor pesticides and heavy metals, which wild mushrooms readily absorb from their natural environment. On the other hand, cultivated mushrooms provide themselves with what they need the most. Using these products, we help restore balance and well-being.
Our products are primarily customised to the needs and health issues of our clients. According to their requests we have chosen the best methods of cultivation, the most appropriate raw materials and the most convenient packaging.
Our high-quality products are the result of continuous biotechnological research and development carried out in collaboration with various national and international research institutions and companies.

Conducting R&D of new products
The efficiency and the quality of our products, which is regularly examined by independent laboratories, as well as the fact that they have a 100% organic origin and are 100% manufactured in the European Union, is what allows different pharmaceutical companies to use them in their own brands of food supplements.
At all times, we strive to offer only products that improve the quality of well-being and health of humans as well as animals as much as possible.
We offer you a 100% natural and a 100% reliable way of helping your body and yourselves.
How our products are produced
MycoMedica Ltd. is developing new fungal products and making existing ones better all the time, this is why we would like to inform you about the composition of heteropolysaccharides and GOBA products containing powders.
Young fungi ready for harvesting
After few years of research a new formula was developed based on a proprietary blend of fresh fruiting bodies and liquid fungal extract sprayed onto a drying agent i.e. organic starch and cellulose containing material, dried and powdered. In case of Cordyceps, Polyporus, Poria and Chaga mycelium and sclerotia are used. Blend is dryed under vacuum at temperatures below 60 degrees Celsius with constant mixing, enabling additional rupture of fungal cell walls and thus enhancing bioavailability of intracellular substances.
Emptying material from after vacuum drying
MycoMedica Ltd. stays one of the best European companies in the field of medicinal fungi production and research with more than 30% of its employees with PhD degree or higher, involved in domestic, as well as international research and development projects and clinical trials.
For more information on our research, please visit https://www.researchgate.net/profile/Andrej-Gregori/research